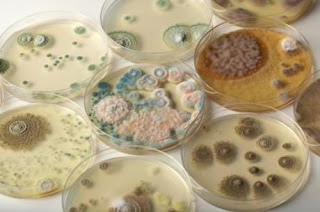

Os surtos de doenças causadas por alimentos ou água contaminados têm como origem em 36,9% dos casos o ambiente doméstico, segundo dados do Ministério da Saúde. Em seguida, aparecem os restaurantes ou lanchonetes (15,8%). O Ministério da Saúde considera surto de DTA (doença transmitida por alimento) casos em que duas ou mais pessoas apresentam sintomas semelhantes após ingerirem alimentos e/ou água da mesma origem, normalmente em um mesmo local. Em 2018, foram ao menos 597 surtos, número praticamente igual a 2017, sendo que 8.406 pessoas ficaram doentes, 916 foram hospitalizadas e nove morreram. Os dados do ano passado ainda são preliminares.No entanto, o número de casos não reportados faz com que, segundo médicos, as infecções alimentares sejam mais comuns do que os números oficiais mostram. A água contaminada é a principal causa (35,8%) dos surtos, seguida de alimentos mistos (16,7%), em que a composição possui mais de um grupo alimentar (por exemplo, uma maionese caseira), segundo o ministério. Três famílias de bactérias respondem por boa parte dos casos de infecção alimentar: Escherichia coli, conhecida como E. coli (24%); Salmonella spp. (11,2%) e Staphylococcus aureus (9,5%). A médica infectologista Raquel Muarrek Garcia, do hospital São Luiz Morumbi, em São Paulo, explica que essas doenças estão quase sempre ligadas à higiene pessoal (lavar as mãos), à qualidade dos alimentos, à manipulação inadequada de determinados alimentos e também à água contaminada. “As bactérias são semelhantes porque provocam doenças diarreicas por ingestão de alimento ou água, inclusive água contaminada usada para lavar alimentos.” Os principais sintomas são: mal-estar, náusea, vômito, diarreia, febre e dores abdominais. “O problema da diarreia é que você perde de 200 ml a 250 ml de água cada vez que vai ao banheiro. Então, sendo muitos esses episódios, você pode não conseguir ingerir essa água de volta e desidratar rapidamente. Há quadros de desidratação que são graves, com choque [convulsões] e queda da pressão arterial”, acrescenta a infectologista.
E. coli
As bactérias E. coli podem provocar sintomas que duram até duas semanas — como é o caso da cepa enteroinvasiva — e incluem disenteria e febre. Já a E. coli entero-hemorrágica evolui de diarreia aquosa até com a presença de sangue. É raro que o paciente apresente febre, mas o vômito é comum. A médica do hospital São Luiz recomenda procurar atendimento médico se a diarreia persistir por alguns dias. “Normalmente, a E. coli faz uma alteração de permeabilidade intestinal e provoca diarreia mais prolongada.”
Salmonella
A salmonelose — doença causada pela Salmonella — tem como característica causar diarreia pastosa, aquosa, podendo ter sangue, além de febre e vômito. Os sintomas duram de cinco a sete dias. As infecções da pela Salmonella, normalmente, têm cura sem necessidade de intervenção médica. A recomendação é repouso, consumo de água e antitérmicos em caso de febre.
Como evitar
As doenças alimentares são causadas principalmente pelo consumo de água contaminada por esgoto, alimentos que não foram lavados de maneira certa, carne não cozida acima de 70°C (por um período de pelo menos 10 minutos), laticínios não pasteurizados, entre outros. Raquel cita alguns hábitos rotineiros que podem fazer com que alguém tenha uma infecção alimentar. “É muito comum em casa as pessoas deixarem a comida fora da geladeira, não limparem a pia, não trocarem as buchas usadas para lavar a louça, usar a mesma tábua de frios para vários tipos de alimentos, não limpar a a geladeira periodicamente.” A Salmonella pode estar em alimentos contaminados com fezes de animais, como no caso das carnes e ovos que não foram cozidos por tempo suficiente. Não lavar as mãos antes de pegar na comida também aumenta o risco de contágio. A pia da cozinha é um local propício para o que se conhece por contaminação cruzada. Uma salada de folhas, por exemplo, se colocada sobre a mesma tábua onde se cortou frango cru, pode provocar infecção por Salmonella.
As condutas para evitar as doenças alimentares incluem:
Utilizar apenas água filtrada, mineral ou fervida para consumo ou para cozinhar;
Lavar frutas, verduras e legumes que forem consumidos in natura com água e água sanitária;
Evitar carnes mal-passadas e ovos com gema mole;
Lavar as mãos antes e durante a manipulação dos alimentos;
Manter limpos geladeira, pia e utensílios usados para cozinhar. (R7/Ba)